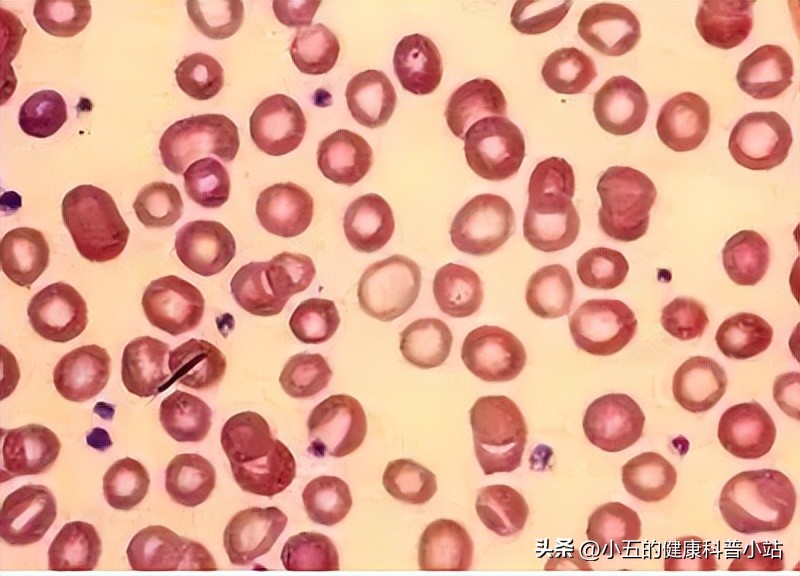
益气养血治疗贫血吗,生血宁片可以治贫血吗

#秋日生活打卡季#
生血宁片是临床常用于治疗气血两虚型缺铁性贫血的常用中成药之一,其具有益气补血,养血生精的作用,对于多种原因造成的缺铁性贫血均具有较好的治疗效果,可以有效提升患者红细胞和血红蛋白的数量,但是许多患者不熟悉生血宁片的服用方法和注意事项,今天就和大家聊一聊这款大品牌中成药。

缺铁性贫血是临床常见的贫血种类之一, 其本质是由于体内铁的储存不能满足正常红细胞生成的需要而发生的贫血, 但由于导致铁元素不足的因素较多,因此临床上可根据具体的原因分为铁元素摄入不足或者铁元素丢失过多2种类型。 临床上缺铁性贫血主要表现为小细胞低色素性贫血,而针对这种疾病临床上以补铁和蛋白质作为主要的治疗手段 。
中医学认为导致缺铁性贫血的关键病机在于气虚不足以运化血液所致, 因此临床上常以补气、健脾、养血、生精等作为治疗缺血性贫血的主要方式 ,而其中气血两虚型贫血占有绝大部分,生 血宁片就是临床上治疗气血两虚型贫血的中成药之一,其具有益气补血,养血生精等多重作用 ,可以有改善患者的贫血状态。
一、生血宁片的组成和作用
生血宁片的主 要成分是从传统中药蚕砂中提取而成 ,而蚕砂其实就是蚕蛾科昆虫家蚕的幼虫的干燥粪便, 中医学认为蚕砂味甘、辛,性温,归属于脾、胃、肝三经,具有祛风除湿,和胃化浊,活血通经等作用 ,临床常用于治疗风湿痹症,肢体麻木,血虚生风等多种病症。特别是对于生血具有特殊作用,这是因为蚕砂可作用于脾、胃、肝三经, 其中脾胃为运化后天之本,可以造血,而肝主行气和藏血,作用于三脏可以以达到行气生血的作用,因此对于血虚导致头晕、肢体麻木等多种症状都有明显的治疗效果 。
二、生血宁片的药理学机制
生血宁片是将蚕砂通过浸提、溶解皂化、抽提、酸析、铁代络合等多重步骤后制成 铁叶绿酸钠及叶绿素衍生物,其具有改善贫血、消炎抑菌、抗肿瘤、降血糖等 多重药理学作用,在治疗缺铁性贫血时其主要的作用机制如下。
1、促进血红蛋白的生成
铁叶绿酸钠是生血宁片的主要成分之一, 其内部含有大量的铁元素,当铁叶绿酸钠在小肠被吸收入血后,可以快速起到补充铁元素的作用,从而促进血液中血红蛋白的很长,并且这种作用不会受到饮食、药物或者二价铁离子等多种因素的影响 ,生物利用率非常高,所以可以快速有效的改善缺铁性贫血。

2、刺激骨髓造血
临床研究表明生血宁片对于红细胞、血小板等多种血细胞都有明显的提升作用, 这是因为生血宁片中的叶绿素衍生物对于骨髓造血具有一定的刺激作用,可以提高外周网织细胞中红细胞的百分比,提高血清铁含量和转铁蛋白的饱和程度 ,从而改善多种血细胞的缺失状态。
3、降低炎症反应
生血宁片具有明显的抗炎、抗氧化作用,可 以有降低氧化应激反应和微炎症反应对于造血系统的影响,保护骨髓的正常造血 。
4、调节机体的铁代谢状态
生血宁片可以有效调整机体中的铁代谢状态, 其可以通过抑制机体的微炎症反应来提高铁调素的表达,进而调节缺铁性贫血患者体内的铁代谢水平,提高机体对于铁元素吸收和利用 ,从而有效治疗贫血。
三、生血宁片临床常用于治疗这几种贫血
中医学认为生血宁片主要治疗的是 气血两虚型缺血性贫血 ,这种贫血的临床主要表现为 面部、肌肤萎黄,神疲乏力,眩晕耳鸣,心悸气短等 。
现代医学认为临床上造成缺血性贫血的原因很多,如老年性缺铁性贫血、肾性贫血、癌症性贫血等,但临床研究表明生血宁片对于多种原因造成的贫血均具有较好的治疗效果。
1、老年性贫血
老年人由于消化系统和造血系统的功能衰退,因此往往会出现缺铁性贫血的表现, 临床研究表明老年人适当补充生血宁片可以有效升高体内红细胞、血红蛋白等多种指标,有效改善贫血状态,同时还可以有效缓解头晕、心慌、肢体麻木等多种由于贫血造成的不适症状 。
2、癌性贫血
癌性贫血指肿瘤患者在其疾病的发展及治疗过程中发生的贫血, 造成这种贫血的原因主要是因为癌症治疗过程中放化疗药物对于骨髓造血系统的抑制和*伤杀**,也可能是癌症患者自身消化吸收功能衰退所造成。 临床研究表明生血宁片可以有效改善癌性贫血,不仅可以提高患者红细胞、血红蛋白等指标,而且可以有效改善骨髓的造血状态,从而降低放化疗的副作用 。

3、肾性贫血
肾性贫血的主要原因是在于肾脏合成的促红细胞生成素分泌减少所造成,导致人体对于铁离子利用和代谢水平下降所造成。 临床研究表明生血宁片可以有效调整肾性贫血患者体内的铁代谢状态,抑制体内的炎症反应,提高体内铁调素的表达,从而纠正机体的铁代谢状态,有效改善肾性贫血 。
4、妊娠期贫血
妊娠期贫血是一种因为孕妇消耗过大,但是补充不足而导致贫血, 临床研究表明生血宁片可以辅助治疗妊娠期贫血,其可以有效提高患者体内红细胞、血红蛋白、转铁蛋白水平及血清铁水平,缓解患者头晕、乏力等多种临床症状 。

四、科学服用生血宁片注意4点
1、注意辨证论治
生血宁片是一种中成药,其使用前一定要经过专业中医师进行辨证论治, 其对于气血两虚型贫血治疗效果较好,但是对于其他证型的贫血治疗效果尚不明确 ,因此建议大家在购买和服用前一定要咨询专业中医师。

2、注意服用剂量和方法
生血宁片的服用方法要根据贫血的程度进行调整。
对于轻度缺铁性贫血患者 ,建议每次2片。每日2次;
对于中、重度贫血的患者 ,建议每次2片,每日3次;
儿童贫血的患者 ,建议每次1片,每日1次。
生血宁片的治疗周期较长, 往往以30天为一个疗程,服用期间要定期监测相关的血液指标 。
3、注意药物的不良反应
服用生血宁片主要的不良反应是消化道反应 ,最常见的就是腹痛、恶心、呕吐、食欲不振等;其次, 极少数患者在服用后会出现皮疹、瘙痒等过敏反应 ;最后, 极少数患者在服用后会出现粒细胞增多的血液异常表现, 但是尚不明确是否与本药相关。
4、注意密封保存
生血宁片必须做到避光、防潮和密封保存 ,因为其非常容易受到潮湿、光照等因素的影响而导致药效下降。
五、总结
生血宁片是临床常用于治疗缺铁性贫血的常用中成药之一,其具有益气补血,养血生精的作用,对于老年性贫血、癌性贫血、肾性贫血等多种原因导致的贫血都有较好的治疗效果,但是服用前一定要经过专业中医师进行辩证论证,同时必须注意服用过程中可能出现的不良反应,建议大家在医生指导下规范用药。